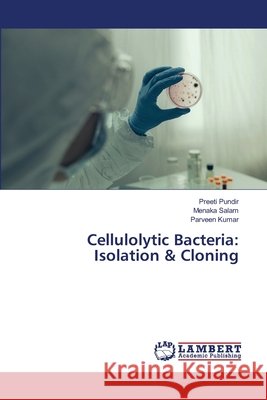
Cellulolytic Bacteria: Isolation & Cloning Pundir, Preeti; Salam, Menaka; Kumar, Parveen 9786202563291

topmenu
Wyniki wyszukiwania:
wyszukanych pozycji: 2
|
Cellulolytic Bacteria: Isolation & Cloning
ISBN: 9786202563291 / Angielski / Miękka / 2020 / 68 str. Termin realizacji zamówienia: ok. 10-14 dni roboczych. |
cena:
180,15 |
 |
Identification of QTLs for Improvement of Salt Tolerance in Rice
ISBN: 9786202555692 / Angielski / Miękka / 2020 / 188 str. Termin realizacji zamówienia: ok. 10-14 dni roboczych. |
cena:
324,63 |










